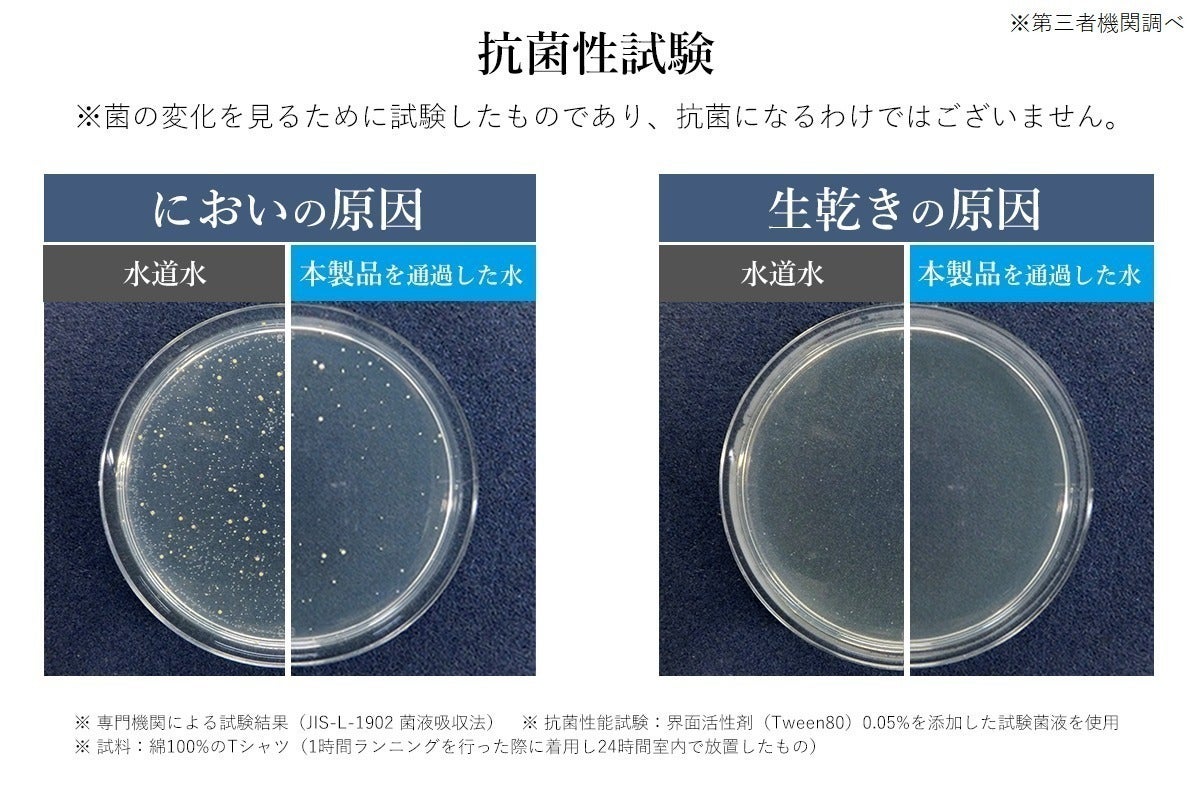

衣類の汚れ、洗濯槽の見えない部分の汚れ、洗濯物のニオイ・・・
その洗濯の悩み、ナノバブルアダプターを取付けるだけで解決しませんか?
▼本製品を洗濯機に取付けた状態

商品要約
●ランニングコストゼロ!ずっと使えて経済的。
●工事、工具不要!取り付けるだけで、洗濯水が1億個のナノバブル水に。
●繊維の奥の汚れ、しつこい部屋干し臭、洗濯槽の裏側の汚れまで徹底ケア!
●日本製。特許取得ナノバブルコアを搭載し、第三者機関でも効果を実証済みで安心!






▼工具不要!取付方法


洗濯について、あなたは...



こんな悩みが、少しでも軽減されたら、いかがですか?

商品説明
ナノバブルとは?
ナノバブル(微細気泡)とは、0.001mm未満の気泡のこと。
マイナス帯電の気泡のため、非常に細かい隙間の奥まで入り込み、イオン吸着することで汚れを浮き上がらせることができると言われています。



ナノバブルは、「洗剤の洗浄成分(界面活性剤)の効果を高めるチカラ」と、「繊維の奥にしっかり浸透して、汚れを落としやすくするチカラ」があると言われています。




 ※ナノバブル発生構造イメージ
※ナノバブル発生構造イメージ
コア装着前と後の比較
ナノバブル発生装置を装着する「前」と「後」で、どのような違いがあるのかを検証した結果です。※下記は、岐阜市の一般家庭の蛇口を全開にした状態です。
▼ナノバブル発生装置 装着前
ストレート状に水が出てきます。

水を流している状態を撮影していますが、見た目では何も変化はありません。

▼ナノバブル発生装置 装着後
扇状に水が出ています。

【ナノバブル発生中】ホース中央に、細く白いトルネードしている泡が見えます。※白い泡がナノバブルではございません(水圧や使用環境により変化します。)


「洗濯機用ナノバブルアダプター」の草分け的存在の髙納商店。第一弾の洗濯機用ナノバブルアダプターを販売してから、4年が経ちました。
ユーザー様からの声として、【衣服や洗濯槽の汚れ落ち】の他にも、【ニオイが軽減した】というお喜びの声をたくさんいただいております。
下記、エビデンス情報を公開いたします。
エビデンス
【結論】汗臭などの嫌なニオイが軽減!
 ※洗濯物の種類・材質・地域の水質・ご使用環境などにより効果は変化することがございます。
※洗濯物の種類・材質・地域の水質・ご使用環境などにより効果は変化することがございます。
※ニオイに関するエビデンス(第三者機関調べ)
【結論】不快なアンモニア臭が軽減!

※洗濯物の種類・材質・地域の水質・ご使用環境などにより効果は変化することがございます。
※ニオイに関するエビデンス(第三者機関調べ)
【結論】部屋干しの嫌なニオイの原因菌を抑制!

※洗濯物の種類・材質・地域の水質・ご使用環境などにより効果は変化することがございます。
※ニオイに関するエビデンス(第三者機関調べ)
【衝撃】120回の洗濯でこんなにキレイに!

※洗濯物の種類・材質・地域の水質・ご使用環境などにより効果は変化することがございます。
※汚れ落ちに関するエビデンス(自社試験)
【衝撃】見えない洗濯槽の裏側がキレイに!

※洗濯物の種類・材質・地域の水質・ご使用環境などにより効果は変化することがございます。
※汚れ落ちに関するエビデンス(自社試験)
【衝撃】洗濯機底部の円盤状部品までも!

※洗濯物の種類・材質・地域の水質・ご使用環境などにより効果は変化することがございます。
※汚れ落ちに関するエビデンス(自社試験)
【驚愕】Yシャツの襟の黄ばみが軽減?!

※洗濯物の種類・材質・地域の水質・ご使用環境などにより効果は変化することがございます。
※汚れ落ちに関するエビデンス(自社試験)
【驚愕】Yシャツに付いた汚れが、落ちてる?!

※洗濯物の種類・材質・地域の水質・ご使用環境などにより効果は変化することがございます。
※汚れ落ちに関するエビデンス(自社試験)
【衝撃】ナノバブル水で洗うと、よく落ちる?!

※洗濯物の種類・材質・地域の水質・ご使用環境などにより効果は変化することがございます。
※汚れ落ちに関するエビデンス(第三者機関調べ)
【事実】洋服の色落ちも、水道水と変わらず!

※色落ちに関するエビデンス(第三者機関調べ)
ご利用者様の声

リターン品について

Q&A
Q.以前の商品(スーパーナノバブルトルネーダSP)と何が違いますか?
A.ナノバブル発生コアが違います。ナノバブル発生コアを改良し、ナノバブル発生数が1億個/mlとなりました(以前は2180万個/ml)。また、特許取得済み・意匠登録済みです。本体は変更しておりませんので、取付け方は同じです。
Q.取り付けられる洗濯機を教えてください。
A.「ドラム式洗濯機」、「縦型洗濯機」は使用可能です。取り付けた際、約5cm上に伸びます。洗濯機の蓋が干渉したり、自動洗剤投入口などの蓋が干渉しないかを予めご確認くださいませ。なお、「二槽式洗濯機」は取付不可となります。
Q.すべての汚れが落ちますか?
A.いいえ。付着物の種類、汚れが付着してからの時間経過、その他の環境により、変わります。洗剤を併用して洗濯されることをおすすめしております。
Q.汚れがひどい場合、どうすれば良いですか?
A.洗濯する前に専用洗剤などを使用し予洗いをするなど、前処理を行うことをおすすめしております。
Q.お風呂の残り湯を使用しても良いですか?
A.ナノバブルを発生させるためには、水が本製品を通過する必要があります。そのため、お風呂の残り湯をご利用いただいた場合は、洗いの際は効果を発揮することができません。「注水すすぎ」の際に、ナノバブル水が出てきます。
Q.塩素は取り除くことができますか?
A.できません。水道水は水を安全に各家庭に届けるため雑菌の繁殖を防ぐために塩素処理をされています。浄水にすると、洗濯後、洗濯槽などに塩素除去された水が溜まり、雑菌が繁殖しやすい環境になる可能性があります。
Q.給水時間が遅くなるのはなぜですか?
A.本製品は、特許構造でナノバブルを発生させております。水の通り道が狭くなっているため節水されます。洗濯機は、洗濯槽内の水量を水位センサーで測っているため、設定水量になるまで通常より時間が掛かるためです。水圧が弱いご家庭でもご利用可能ですが、さらに時間が掛かる可能性がございますので、予めご了承くださいませ。
Q.定期的に商品を交換する必要はありますか?
A.カートリッジ式ではございませんので、取り替えは不要です。
Q.洗濯や洗濯物を干す際、気を付けることはありますか?
A.洗濯機に洗濯物を詰め込みすぎないこと。洗濯が終わったらすぐに干すこと。洗濯物同士の間隔をあけて、風通しを良くして干すこと、をおすすめします。また、40℃程のお湯を使用して洗濯してみることも皮脂汚れなどにおすすめです。
Q.洗濯終了後に、気を付けることはありますか?
A.洗濯終了後は、給水栓(蛇口)を閉めていただく事を推奨しております。取付けがゆるく、水漏れが発生した場合、水が流れっぱなしになります。ゆるくなっていないか定期的にご確認くださいませ。また、洗濯後にフタを開けておくことをおすすめしております。フタを開けておくことで湿気を飛ばし、洗濯機内部を乾かすことができます。十分に乾かすことで、カビの防止にもなります。
開発者・生産地について
岐阜県に拠点を構える有限会社高納商店が開発した「改良版・洗濯機用ナノバブルアダプター」は、今お使いの洗濯機に取り付けるだけで、ナノバブル水に変換するアダプターです。
弊社は長年、LPガス・灯油の販売、住宅設備機器・リフォーム・配管工事を行う同社は、金華山などの山々や、長良川に囲まれる「清流」岐阜県で常にお客様と真摯に向き合ってきました。
私たちは常に「日本製(Made in Japan)」にこだわっています。最終組み立て・梱包・発送手続きまで岐阜県内にて行い、ご購入いただいたお客様へお届けいたします。

当社、NANORISMラボにて開発・製造しております。

岐阜県は、古くからものづくりがさかんで、製造業は中心的な産業です。工業部品から生活雑貨まで、毎日の暮らしを豊かにするあらゆる製品が、自然豊かな岐阜の大地から生まれています。
本製品の本体は「水栓バルブ発祥の地」で製造しております。

水まわり製品(給水栓や浄水器、シャワーヘッドなど)の製造メーカーに勤めていた経験と、ナノバブルの研究開発を続けている発明者の融合により、本製品が誕生しました。

※毛髪診断士は、公益社団法人日本毛髪科学協会の商標登録です。
また、ライフスタイル比較メディア「Amebaチョイス」にて、浄水器の専門家として、過去に浄水器の監修もさせて頂いております。

この度、弊社オリジナルのナノバブル製品ブランド「NANORISM(ナノリズム)」を立ち上げました。
"NANORISM"とは、「ナノバブル」×「生活を豊かにするアイテム」というコンセプトのもと、2つの潤い(水で潤う・生活が潤う)をご提供したい想いが込められております。
今後、NANORISMブランドの製品をどんどん開発してまいりますので、どうぞご期待くださいませ。

最後に
ここまで読み進めていただきまして、誠にありがとうございました。
今回、改良版・洗濯機用ナノバブルアダプターをリリースできたのも、これまでにご購入いただきましたお客様のおかげでございます。この場をお借りして、深く感謝申し上げます。本当にありがとうございます。
今回のプロジェクトは、特許取得済み・意匠登録済みのナノバブル発生コアを使用した日本製「洗濯機用ナノバブルアダプター」です。すべての部品は国内産、企画・デザイン・商品化まですべて日本の会社が日本国内で実施しております。水の性質は肉眼では見えませんが、第三者機関による各種テストに時間と費用をかけ、試行錯誤を繰り返し、ようやく完成した製品をぜひ皆様にご体感頂けますと嬉しいです。
本プロジェクトは、お客様への恩返しの気持ちと、多くの方に使用して頂きたい想いから、なるべく安価に販売できるように調整いたしました。
今回のプロジェクトで集められた資金は、リターンの作成にかかる費用に充てられる他、各種テストの費用や、今後の新たな製品づくりの資金に充てたいと考えております。次回のプロジェクトも乞うご期待くださいませ。
このプロジェクトを通して、みなさまと繋がることができ、本当に嬉しく感じております。
最後まで読んでいただき、ありがとうございました。


◾️特定商取引法に関する記載
●販売事業者名:有限会社髙納商店
●通信販売に関する業務の責任者:高納誠知
●事業者の住所:〒502-0908 岐阜市近島2-7-16
●事業者の連絡先:メッセージ機能にてご連絡ください
●リターン価格:各リターン記載の通り *商品内容についてはリターン欄記載の通り
※リターン価格とは別にCAMPFIRE(machi-ya)のシステム利用料として、支援金額1万円未満の場合は250円(税込)/ 1万円以上の場合は支援額の2.5%(税込)が支援者様の負担となります。
※上記システム利用料はCAMPFIREが受け取るもので、当社が受領するものではございません。
●送料:送料込み(離島価格など例外がある場合には記載)
●対価以外に必要な費用:プロジェクトページ、リターンに記載のとおり。
●支払い方法:CAMPFIREの決済手段に準ずる。(詳細は https://help.camp-fire.jp/hc/ja/articles/234485888 )
●支払い時期:当プロジェクトは「All-in型」の為、目標達成の如何に問わず、ご契約が成立しリターンをお届けします。その為、お申込みと同時にご利用の決済方法に準じてご請求となります。
●引渡し時期: 各リターン詳細に記載の発送予定月を引き渡し時期とします。但し、開発・生産状況によって遅れが生じる場合がありますのでその際は当プロジェクトページ内の「活動報告」または購入者へのメール等で連絡します。
●キャンセル・返品: 当プロジェクトは「All-in型」の為、お申込み完了をもって契約が成立いたします。その為、お客様都合による返品・キャンセルはできませんのでご注意ください。尚、製品到着後に破損や初期不良がある場合には交換させていただきますので「メッセージで意見や問い合わせを送る」から、または納品書記載の連絡先までお問い合わせください。
●ソフトウェアに係る取引である場合のソフトウェアの動作環境:該当なし
●その他記載事項:プロジェクトページ、リターン記載欄、共通記載欄(https://camp-fire.jp/legal)をご確認ください。
最新の活動報告
もっと見るご支援の御礼と、出荷時期について
2025/12/18 09:41こちらの活動報告は支援者限定の公開です。

コメント
もっと見る